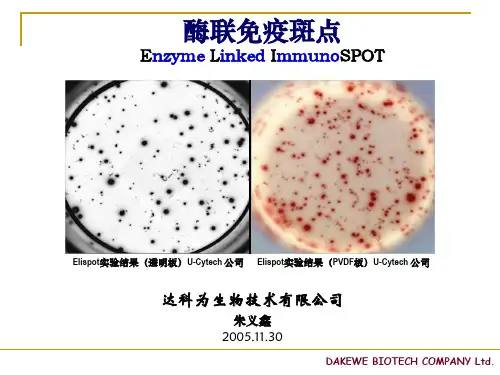

ELISPOT技术应用简介
- 格式:pptx
- 大小:4.75 MB
- 文档页数:54

Elispot的原理及应用1. Elispot是什么Elispot(enzyme-linked immune spot assay)是一种用于测定单个细胞的分泌功能的实验技术。
它通过检测分泌细胞在特定条件下产生的细胞因子或细胞分泌物的分泌量,来评估细胞的免疫反应。
Elispot被广泛应用于免疫学、肿瘤学、感染病学等领域的研究和诊断。
2. Elispot的原理Elispot基于细胞分泌物的分泌原理进行测定。
其原理主要包括以下几个步骤:1.准备ELISPOT板:将特定抗体或刺激物涂覆在固相支持体上,形成抗原或刺激物捕获层。
常用固相支持体有多孔膜、96孔板等。
2.加样细胞:将待测细胞或其他产生细胞分泌物的细胞加入到ELISPOT板中,使其与抗原或刺激物接触。
3.细胞刺激:经过一定的培养条件和时间,刺激细胞产生分泌物。
4.分泌物检测:将细胞移除,用特异性抗体标记待测细胞分泌物中的目标分子,形成复合物。
5.免疫反应可见化:通过酶标法或荧光法,使复合物与ELISPOT板上的底物发生反应,产生可观察的斑点。
3. Elispot的应用Elispot技术广泛应用于以下领域:3.1 免疫学研究Elispot可以用于研究多种细胞因子的产生情况,如干扰素γ(IFN-γ)、白介素-2(IL-2)、肿瘤坏死因子(TNF-α)等。
它可以检测单个细胞的分泌情况,并通过对不同细胞类型进行比较,揭示免疫细胞的功能和相互作用。
3.2 肿瘤学研究Elispot可以评估肿瘤特异性T细胞的活性和功能。
通过使用与肿瘤相关的抗原刺激细胞,可以检测肿瘤特异性T细胞的分泌情况,进而评估免疫治疗的效果和抗肿瘤免疫应答的强度。
3.3 感染病学研究Elispot在感染病学研究中起到重要作用。
通过检测特定感染病原体的抗原刺激下,细胞分泌物的产生情况,可以评估免疫应答的强度和类型,并且可以用于疫苗开发和新药筛选等领域。
3.4 自身免疫性疾病研究Elispot可以用于评估自身免疫性疾病(如类风湿性关节炎、系统性红斑狼疮等)患者的自身免疫反应。


探究细胞免疫过氧化物酶的单层实验技术原
理
免疫过氧化物酶单层细胞实验技术(简称ELISPOT技术)是一种
用于植物、动物和人体细胞免疫功能研究的先进技术。
使用这种技术
可以检测特定单个细胞所产生的蛋白质,尤其是细胞因子。
下面我们
来详细了解一下这个技术的原理:
首先,我们需要准备两个特定抗体:用于先后标记目标抗原的一
级抗体和用于探测一级抗体的二级抗体。
一级抗体绑定特定的细胞刺
激分子,二级抗体则结合一级抗体,使可见的单层反应产物形成。
接下来,将一定数量的细胞孵育在含体积固定的高浓度一级抗体
盘中。
细胞在该盘中沉淀形成单层,随后将其孵育。
在孵育的过程中,给细胞补充适当的物质用以刺激细胞因子的释放。
一级抗体可以捕捉
这些细胞因子,从而实现实验的目的。
接着,在单层的细胞上加入一定量的二级抗体。
由于二级抗体已
经标记了特殊的酶,可以很容易地鉴定单层上的细胞因子或抗原。
之后,显色液位盖在反应孔上,反应时间15至20分钟。
接着去除显色
液并使用稀释液洗涤,洗涤后观察条带或点,如果呈现出灰白或深蓝色,则代表着该点或条带中存在该抗原的细胞因子。
除了上述方法之外,ELISPOT还能够用于测定体内特定腺病毒对T
细胞的免疫刺激反应,以及对单核细胞亚群和调节细胞的分析研究等。
总结起来,免疫过氧化物酶单层细胞实验技术可以通过检测每个单个的细胞所分泌的细胞因子进行准确的结果测定。
该技术对研究免疫学和感染性疾病等领域都有着重要的应用价值。
通过不断优化实验流程和研发新的检测方法,相信该技术将在未来得到更广泛的应用。

ELIspot技术检测结核分枝杆菌感染检测原理检测原理是:机体感染结核分枝杆菌后,存在于血液中的特异性效应T淋巴细胞会在再次接触结核分枝杆菌特异抗原时,产生和分泌IFN-γ,通过检测能够释放IFN-γ的T淋巴细胞数量,用于结核分枝杆菌感染及结核病的辅助诊断。
该检测方法相对于结核菌素试验,具有更高的特异性。
由于结核菌素试验中用的结核菌素是从结核分枝杆菌中提取的非种属特异的性分子,因此存在与卡介苗(BCG)的交叉,接种过BCG的人群即使没有感染结核也可能会出现结核菌素试验阳性。
而ELIspot检测所用的结核分枝杆菌特异抗原与BCG抗原无交叉,不受BCG接种的影响,未接种BCG和接种BCG的人群均可用该法进行结核病感染的筛查和结核病的辅助诊断。
目前应用的ELIspot检测试剂盒是由英国Oxford Immunotec公司生产的T-SPOT®TB试剂盒。
其检测方法如下:1.抗体包被将适量人IFN-γ抗体预先包被于96孔ELIspot板上。
2.标本采集及准备采集8小时内的肝素抗凝血,用Ficol离心分离外周血单核细胞(PBMC),用细胞培养液洗涤2次后,重悬于细胞培养液中。
3.细胞计数及稀释用台盼蓝染色计数法对PBMC细胞悬液计数,将细胞悬液浓度调整至2.5×105个细胞/100μl。
4.抗原刺激及孵育每个待检样本均需设阳性对照孔、阴性对照孔和检测孔。
阳性对照孔加入植物血凝素(PHA)作为阳性刺激抗原,阴性对照孔不加任何抗原刺激,检测孔加入结核特异性抗原。
若有几个特异性抗原进行分别刺激,检测孔可根据需要设置多个孔。
向阳性、阴性对照孔及检测孔内各加入100μl的PBMC细胞悬液,将ELIspot板置于37℃5%CO2培养箱内静置孵育16~20小时。
孵育期间不能移动ELIspot板,必须保证板静置不动。
5.斑点显色及计数弃除板内的细胞培养液,每孔加入200μl的PBS缓冲液洗涤3~5次,弃净板内的液体,向每孔加入100μl稀释好的生物素标记抗体,37℃孵育1小时。

酶联免疫斑点试验
酶联免疫斑点试验(Enzyme-Linked Immunosorbent Assay,简称ELISPOT)是一种高灵敏度的免疫学检测技术,可用于检测单个细胞
的分泌物,如细胞因子、抗体、酶等。
该技术广泛应用于疾病诊断、
药物筛选、疫苗研究等领域。
ELISPOT的原理是利用特定的抗体捕获分泌物,然后使用酶标记的二
抗或底物来检测捕获的分泌物。
具体步骤如下:
1. 准备试板:将多孔板涂上特定的抗体,使其能够捕获分泌物。
2. 细胞处理:将待检测的细胞加入试板中,使其与涂有抗体的孔相互
作用。
3. 洗涤:将试板洗涤,去除未结合的细胞和其他杂质。
4. 二抗标记:加入酶标记的二抗,使其与捕获的分泌物结合。
5. 洗涤:将试板洗涤,去除未结合的二抗和其他杂质。
6. 底物反应:加入底物,使其与酶标记的二抗反应,产生可见的斑点。
ELISPOT的优点是灵敏度高、特异性好、操作简单、结果可靠。
它可
以检测单个细胞的分泌物,因此可以用于研究细胞免疫应答、肿瘤免
疫学、感染病毒的免疫学等领域。
此外,ELISPOT还可以用于药物筛
选和疫苗研究,帮助科学家们开发更有效的药物和疫苗。
ELISPOT的缺点是需要较长的实验时间和较高的成本,同时需要专业
的实验技能和设备。
此外,ELISPOT只能检测单个细胞的分泌物,无
法检测细胞表面分子的表达情况。
总之,ELISPOT是一种重要的免疫学检测技术,具有广泛的应用前景。
随着技术的不断发展,ELISPOT将会在疾病诊断、药物筛选、疫苗研
究等领域发挥越来越重要的作用。

ELISPOT工作原理ELISPOT是一种基于酶联免疫斑点(enzyme-linked immunospot)技术的生物学实验方法,用于检测单个活细胞产生的细胞因子数量,以获得关于特定免疫反应的定量信息。
ELISPOT方法已成为研究和临床诊断中常用的细胞免疫分析技术。
本文旨在介绍ELISPOT技术的原理和应用。
1. ELISPOT技术的基本原理ELISPOT技术的基本原理是利用单个细胞在聚焦区域中分泌细胞因子的能力。
首先在多孔板上涂覆特定抗体,并使用细胞悬浮液孵育,使细胞吸附在多孔板上,然后刺激细胞产生细胞因子,特异性抗体识别并结合细胞因子,供试细胞被固定,而其产生的细胞因子仍然可扩散进入周围。
接着使用酶标技术,添加酶标抗体-酶复合物识别并结合周围可扩散的细胞因子,形成可被酶底物着色的斑点。
ELISPOT试验可用于检测细胞因子的免疫反应,可以在不光化细胞,也无需使用放射性同位素进行标记的情况下,测定非常微量的细胞因子。
2. ELISPOT技术的应用ELISPOT技术的应用非常广泛,可以用于研究细胞免疫学、癌症、感染病原体和自身免疫性疾病等。
下面将分别介绍这些应用。
2.1. 研究细胞免疫学ELISPOT技术可以用于检测不同和同种发育阶段、性别、某些基因型或特定条件下的免疫细胞产生的细胞因子。
例如,可以对不同的激活剂进行测试,检测免疫细胞的分泌情况,揭示特定免疫反应的机制。
此外,由于ELISPOT对特异性和非特异性T和B淋巴细胞的敏感性非常高,所以可以使用这种技术来监测疫苗接种效果或者进行不同细胞因子分子和癌细胞的功能评估等。
2.2. 癌症的研究和治疗免疫疗法已成为一种治疗恶性肿瘤的新式方法,其中包括活体细胞治疗和肿瘤抗原刺激,此类方法具有极大的潜力来抑制肿瘤细胞的增长和扩散。
ELISPOT技术用于评估肿瘤抗原特异性T细胞水平的变化,可以在研究和临床实验中确定特异性的肿瘤抗原。
ELISPOT技术具体可用于肿瘤特异性免疫反应的检测、克隆增殖能力的测定、转移性肿瘤特异性T细胞反应的检测,以及抗肿瘤免疫反应治疗效果的评估等。

酶联免疫斑点法酶联免疫斑点法(Enzyme-linked immunospot assay, ELISPOT)是一种用于检测单个细胞分泌物(包括细胞因子、抗体和其他蛋白质)的方法。
该技术将单个细胞和特异性抗体共同培养于多孔的固体基质上,当特异性抗体捕获了细胞分泌物时,就会形成一个“免疫斑点”,而该斑点会通过化学反应显示出来,从而可进行定量分析。
该技术的优点一是提高了灵敏度和特异性,促进了单个细胞分泌物的检测能力。
二是实验条件较容易控制,能够极大地减少误差。
另外,与其他技术相比,ELISPOT技术具有较高的自动化水平和适应性。
同时,该技术可用于评估和比较不同治疗方案或疫苗的效果、评估细胞免疫反应、疾病诊断和监测、评估药物毒性和进行基础研究。
在实验中,ELISPOT可分为两个阶段。
第一阶段是细胞培养,即将感兴趣的细胞和特定的刺激物共同培养。
第二阶段是免疫斑点检测,即将细胞移到多孔的固体基质上,添加特异性抗体进行反应,以发现并定量斑点。
常用的免疫斑点计数仪可以通过电子显微镜对固定、染色的免疫斑点进行准确计数,从而获得准确的结果。
通过该技术,研究人员可以研究细胞免疫和疫苗的作用机制,及早发现传染病或肿瘤的预警信号,以促进更好的预防和治疗。
此外,酶联免疫斑点法也适用于儿童疫苗接种后对疫情的监测和跟踪,以及老年人免疫力的评估。
需要指出的是,这种技术并不能够直接用于临床检测,仅在研究领域发挥作用。
一些商业实验室已经开始使用该技术进行疫苗测试和特定蛋白质的检测,在检测和诊断方面具有很大的潜力。
总之,酶联免疫斑点法是一种基于细胞分泌物检测的技术手段,在生物医学研究、药物开发以及疾病预防和治疗等方面具有较为重要的应用价值。
酶联免疫斑点技术介绍一、 ELISPOT技术概述1. 技术原理和技术特点ELISPOT全名为酶联免疫斑点检测,英文:Enzyme-linked Immunospot Assay。
它结合了细胞培养技术与酶联免疫吸附技术(即ELISA技术),能够在单细胞水平检测细胞因子的分泌情况。
其技术原理,一句话概括就是:用抗体捕获培养中的细胞分泌的细胞因子,并以酶联斑点显色的方式将其表现出来(Sedgwick JD 2005)。
该技术检测细胞因子具有三大优点:其一,灵敏度高。
在一百万个阴性细胞中只要有一个分泌细胞因子的阳性细胞即可被检测出来。
这是目前为止,最为灵敏的检测技术,灵敏度比传统的的ELISA方法高2-3个数量级。
其二,单细胞水平,活细胞功能检测。
ELISPOT检测的是单个细胞分泌,而非细胞群体的平均分泌。
在检测的过程中,有活细胞培养与抗原刺激阶段,检测的是活细胞的功能,而非死细胞的遗留物。
其三,操作简便经济,可以进行高筒量筛选。
ELISPOT没有复杂的细胞体外扩增过程,不使用同位素,不需要大型的、专门的实验仪器设备。
按照标准化的实验操作,一个实验者可以同时处理数百个样品,效率远远高于其它检测方法(Kalyuzhny AE 2005)。
实验设计在96孔培养板上进行,直接以培养板的塑料板底或者PVDF膜以及硝酸纤维素膜为基质,包被上特异性的单克隆抗体,用以捕获细胞分泌的细胞因子。
(由于涉及到细胞培养的过程,对单克隆抗体的要求要远高于ELISA中的捕获抗体,该抗体需要无毒,不含内毒素,亲和力高等特点。
)之后,在培养板的孔内加入细胞培养基(现在无血清ELISPOT技术已经成熟,培养基中可以不再含有血清)、待检测的细胞以及抗原刺激物进行培养。
在特异性的抗原或者非特异性的有丝分裂原的刺激下,数小时之内,T细胞就会开始分泌各种细胞因子。
细胞因子当即就被位于细胞下方的膜上的单克隆抗体所捕获。
在洗去细胞之后,被捕获的细胞因子可以与生物素标记的第二抗体结合,然后用酶标亲和素再与生物素结合,进行化学酶联显色,就可以在膜的局部形成一个个圆形的斑点。